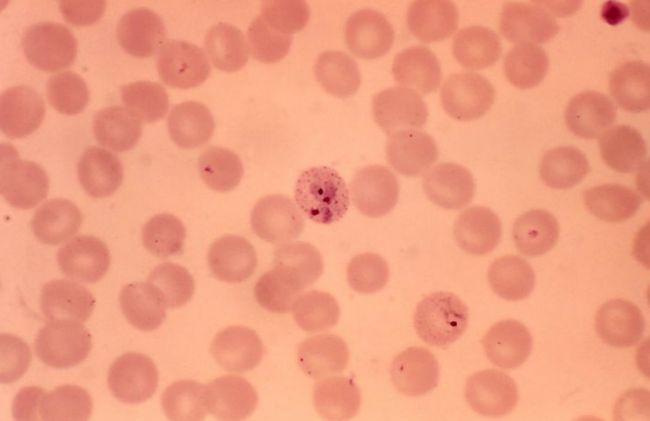
globulos-rojos-palidos

Ya estamos atendiendo nuevamente comuniquese con nosotros por whatsapp al +51 - 973586834 para recibir nuestros tratamientos.
Entérate qué es la anemia por deficiencia de hierro en niños y evita que tu hijo sufra de problemas en su crecimiento y desarrollo corporal y mental.
Conoce cuáles son los síntomas, las consecuencias y como curar la anemia en niños

Según University of Rijcka, la anemia por deficiencia de hierro o anemia ferropénica en niños es una situación en la que el cuerpo carece de hierro suficiente para mantener las funciones normales.
La deficiencia de hierro se define como una reducción de un mineral, el hierro corporal total o por un nivel de ferritina sérica menor a 12 mg/ l hasta los 5 años y menor a 15 mg/ dl en niños mayores de 5 años.
La ferritina sérica representa el hierro que existe en el organismo del niño.
Este indicador será válido siempre y cuando el niño no presente enfermedades que afectan este valor como inflamación o problemas de hígado.
La anemia, ocurre cuando el hierro es demasiado bajo para mantener la producción de glóbulos rojos.
La anemia se define por un valor de hemoglobina dos veces más bajo que el valor de referencia para la edad y sexo.
De acuerdo a la Organización Mundial de la Salud, los valores que indican anemia según la edad, son:

La prevalencia de anemia por deficiencia de hierro en niños en países industrializados es de 8%. Sin embargo, alcanza a 45-65% en África, sudeste asiático y América Latina.
Los factores de riesgo para su desarrollo en niños incluyen el rápido crecimiento, factores de riesgo antes del nacimiento, bajo peso al nacer, niños prematuros y obesidad infantil.
Los más preocupantes y prevenibles son el pobre consumo de hierro y la pérdida de sangre gastrointestinal a causa de un consumo excesivo de leche de vaca y parásitos.
Los bebés que toman leche de vaca, en reemplazo de la materna, tienen un mayor riesgo de anemia por deficiencia de hierro porque el calcio de la leche de vaca compite con el hierro por su absorción.
En niñas que se acercan a la adolescencia pueden ocurrir pérdidas de sangre menstrual abundantes, competencias deportivas, enfermedades crónicas que conducen a anemia. (1)
Si tu quieres evitar que las perdidas de sangre y hierro superen al aporte de hierro en la dieta de tus niños y adolescentes es importante que comiences a incrementar el hierro en su alimentación a partir de ahora.
Una buena forma de hacerlo es a traves de sus desayunos, prepara a tu niños desayunos completos ricos en hierro de rapida absorción y facilmente aceptables en forma de mousse. Aprende como elaborar estos desayunos con las recetas de nuestro Libro, haz clic en el link: Libro de Desayunos Verdes.

De acuerdo a Inha University, los niños pueden experimentar fatiga, problemas cognitivos, disminución de la energía, palidez lenta y progresiva de las mucosas de la boca, ojos.
El niño presenta coloniquias (uñas en forma de cuchara), glositis (inflamación de la lengua) y estomatitis angular (boqueras)
En casos severos el niño se torna irritable, adormecido, aumenta su frecuencia respiratoria.
Los niños con anemia además ven afectado su desarrollo psicomotor, mental, la inmunidad, se afecta su capacidad para realizar ejercicio, se sienten débiles.
En niños mayores suele presentarse el síndrome de piernas inquietas, necesidad incontrolable de mover las piernas y dolor de cabeza.
Cuando las madres consultaron junto a sus niños a médicos en el hospital los síntomas más frecuentes fueron inespecíficos como problemas respiratorios como resfrío, obstrucción nasal.
También síntomas gastrointestinales como vómitos, diarrea, dolor abdominal en un 46%.
Solo el 7% de las consultas fueron debido a los síntomas que mencionamos y en algunos casos no se presentaron síntomas y la anemia se diagnosticó por un análisis de sangre. (2)

Las consecuencias más graves y alarmantes de la deficiencia de hierro en niños son las alteraciones en el rendimiento cognitivo, las habilidades de aprendizaje, problemas físicos y de conducta.
Se evidencio que los cambios cognitivos pueden persistir en el tiempo aun cuando se han recuperados las reservas de hierro cuando la deficiencia de hierro fue de moderada a severa.
Los problemas cognitivos ocurren porque la deficiencia de hierro disminuye la expresión de receptores de dopamina, interrumpe la función de enzimas del sistema nervioso.
Lo cual altera la energía cerebral y disminuye la mielina lo que afecta la vista y oído y las funciones mentales.

De acuerdo a un estudio realizado en Hôpital Robert Debré, la anemia en niños mayores conduce a estos problemas que ocurren entre el 5 y 10% de los niños.
Los niños son impulsivos, tienen problemas para prestar atención y para cumplir con tareas, estos síntomas pueden persistir entre el 30 a 50% de los niños cuando son adultos. (3)

La deficiencia de hierro altera las funciones de las células de defensa como los linfocitos y la producción de sustancias inflamatorias.
Los suplementos de hierro en esta situación puede conducir al crecimiento de bacterias, por lo cual la alimentación resulta una herramienta efectiva para regular el hierro que se aporta.

El hierro es necesario para el ejercicio aeróbico, en ausencia de hierro los músculos utilizan el metabolismo anaeróbico.
Esto puede conducir a una disminución de la capacidad de ejercicio y explica el cansancio, fatiga, y falta de energía que experimentan los niños.

La deficiencia de hierro aumenta el riesgo trombótico, es decir la formación de coágulos de sangre que causan obstrucción de las arterias.
La deficiencia de hierro produce un estado procoagulante que afecta el flujo sanguíneo, aumenta el estrés metabólico en el cerebro donde se encuentran arterias importantes.

El Tratamiento de anemia en niños tiene como objetivo identificar y eliminar la causa que generó la anemia, mejorar la nutrición y alimentación.
El consumo de leche de vaca sin modificar antes de los 12 meses y la pérdida oculta de sangre intestinal por colitis producto de la leche son factores a modificar.
Un consumo inadecuado de hierro es frecuente en la infancia cuando los bebés se alimentan con fórmulas infantiles o alimentos de transición que no son fuentes de hierro es otro factor que conduce a anemia.
La disponibilidad del hierro para su absorción influye, en el sentido de que la leche materna contiene entre 0,3 y 1 mg/ l de hierro con una biodisponibilidad del 50%.
Identificar la presencia de enfermedades gastrointestinales es necesario, existen enfermedades como la celiaquía, Crohn que afectan la absorción de hierro en el intestino.
Las enfermedades gastrointestinales también pueden ocurrir por el uso crónico de antiinflamatorios no esteroideos.
En países en vía de desarrollo se ha evidenciado que la prevalencia de anemia continúa elevada aún con la inclusión de alimentos fortificados.
Es por esto que considerar estos alimentos como suficientes para prevenir y tratar la anemia es un error, conozcamos cómo curar la anemia en forma efectiva.
Implementar la lactancia materna es importante en los primeros meses, brinda suficiente hierro en el primer mes de vida.
Esto se logra también con el pinzamiento tardío del cordón umbilical a los 120 a 180 segundos luego del parto que mejora la cantidad de hierro que recibe el niño.
El hierro en la sangre del cordón umbilical se relaciona con el estado de salud y ausencia de anemia en la madre.
En el caso de que el niño reciba leche de vaca y esta no pueda suspenderse, debe recibir más hierro que el que pierde diariamente para mantener un hierro normal.
En el caso de que la deficiencia de hierro continue, deberá suspenderse la leche y posiblemente los lácteos y reemplazar por otras fuentes de calcio en la dieta.
Asegurar un buen aporte de hierro en la dieta es necesario luego de los 6 meses de lactancia materna exclusiva cuidando la combinación para asegurar la absorción intestinal de hierro.
Los niños deben tomar una dieta adecuada a sus requerimientos de hierro para lo cual requieren seguimiento de una especialista en nutrición para asegurar el aporte y absorción.
Los requerimientos de hierro diario son de 0,6 mg/ día para bebes sanos y 0,8 mg/ día para niños.
Puede calcularse el requerimiento individual del niño hasta los 12 meses puede usarse la siguiente fórmula 1 mg/kg/ día hasta 15 mg, en prematuros de 2 a 4 mg/ kg/ día.
En niños de:
De acuerdo a un estudio realizado en American Academy of Pediatrics, alimentos ricos en hierro que permiten cubrir los requerimientos y mejorar la absorción son:
Nuevas Evas ha desarrollado un Libro de Desayunos Verdes que cuenta con una sección de desayunos rico en hierro para niños, donde encontrarás deliciosos mousses para los más chiquitos de la familia.
Los Desayunos Verdes integran alimentos fuentes de hierro con frutas y verduras ricas en vitaminas facilitadoras como cítricos naranja, pomelo, piña, fresas, melón, kiwi, frutos rojos.
Verduras como pimientos, brócoli, tomate, coles, papas, verduras de hoja verde, coliflor. Comienza a disfrutar de los Desayunos Verdes presionando en el siguiente link: Libro de Desayunos Verdes